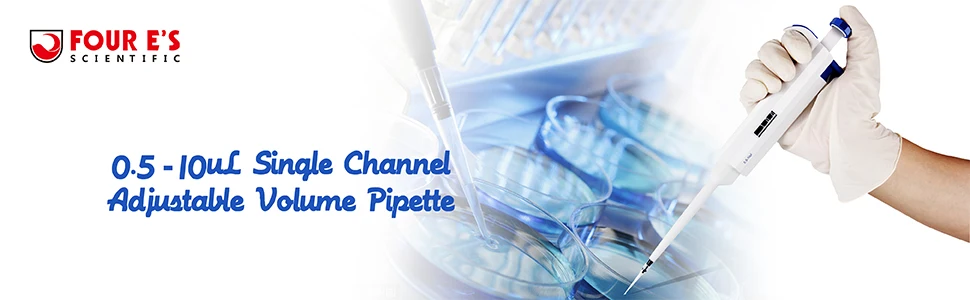

Микропипетка 0 5-10 мкл микропипетка с регулируемым объемом одноканальная пипетка
Сохраните в закладки:






История цены
*История изменения цены! Указанная стоимость возможно, уже изменилось. Проверить текущую цену - >
| Месяц | Минимальная цена | Макс. стоимость | Цена |
|---|---|---|---|
| Mar-19-2026 | 0.39 руб. | 0.67 руб. | 0 руб. |
| Feb-19-2026 | 0.77 руб. | 0.20 руб. | 0 руб. |
| Jan-19-2026 | 0.21 руб. | 0.33 руб. | 0 руб. |
| Dec-19-2025 | 0.20 руб. | 0.4 руб. | 0 руб. |
| Nov-19-2025 | 0.59 руб. | 0.40 руб. | 0 руб. |
| Oct-19-2025 | 0.65 руб. | 0.66 руб. | 0 руб. |
| Sep-19-2025 | 0.51 руб. | 0.94 руб. | 0 руб. |
| Aug-19-2025 | 0.0 руб. | 0.16 руб. | 0 руб. |
| Jul-19-2025 | 0.60 руб. | 0.72 руб. | 0 руб. |
Новые товары
24/40 400 мм конденсатор Allihn шарового типа химия лабораторное оборудование - купить
20 шт 30 одноразовый пластиковый стерильный шприц для инъекций жидкостной с иглой
Тандемная пустая ионная колонка с пустой ионной колонкой 1cc & PE Frits образцы
1 шт. лабораторная 24 # стеклянная пескоструйная хроматографическая Колонка со
Стеклянная градуированная пипетка объемом 0 5 мл/1 мл/2 мл/3 мл/5 мл/10 мл переносная
1 шт. лабораторный многоразовый держатель PTFE 25 мм 37 40 47 для микропористого
Шприц для микропробоотборника шприц микро-инжектора 25 мкл острый наконечник 0 025
Микропористые мембранные фильтры MCE диаметром 50 мм Micro мембраны фильтров размер
Характеристики
Микропипетка 0 5-10 мкл микропипетка с регулируемым объемом одноканальная пипетка
Описание товара
Характеристика:
Диапазон громкости: 0,5-10 мкл;
Приращение: 0.1мкл;
Эргономичный дизайн.
Цифровой дисплей четко читает настройки громкости.
Легко откалибровать и поддерживать с помощью поставляемого инструмента.
Безопасный конусный наконечник может предотвратить внутреннее загрязнение и повреждение пипетки.
Наконечник может быть автоклавным (121 °C, 20 минут)
Услуги по калибровке, обслуживанию и ремонту могут быть доступны для продления срока службы и обеспечения непрерывной точности.
Характеристики:
Характеристика:
Диапазон громкости: 0,5-10 мкл;
Приращение: 0.1мкл;
Эргономичный дизайн.
Цифровой дисплей четко читает настройки громкости.
Легко откалибровать и поддерживать с помощью поставляемого инструмента.
Безопасный конусный наконечник может предотвратить внутреннее загрязнение и повреждение пипетки.
Наконечник может быть автоклавным (121 °C, 20 минут)
Услуги по калибровке, обслуживанию и ремонту могут быть доступны для продления срока службы и обеспечения непрерывной точности.
Характеристики:
Одноканальный регулируемый объем пипетки
Код
Диапазон громкости
Увеличение
Максимально допустимая систематическая ошибка
(Неточность)
Максимально допустимая случайная ошибка
(Неточность)
TB-GP-01
0,1-2.5мкл
0.05ul
± 2.5%
0,02
TB-GP-02
0,5-10 мкл
0.1ul
± 1.0%
0.80%
TB-GP-03
2-20 мкл
0.5ul
± 0.9%
0,004
TB-GP-04
5-50 мкл
0.5ul
± 0.6%
0.30%
TB-GP-05
10-100 мкл
1ul
± 0.8%
0,0015
TB-GP-06
20-200мкл
1ul
± 0.6%
0.15%
TB-GP-07
100-1000мкл
5ul
± 0.6%
0,002
TB-GP-08
1000-5000мкл
50ul
± 0.5%
0.15%
TB-GP-09
1-10 мл
100ul
± 0.6%
0,002











Что находится в коробке?
1 * одноканальные пипетки
1 * калибровочный инструмент
1 * инструкции
1 * наконечник




 Компания FOUR E'S SCIENTIFIC основана для обслуживания лабораторного рынка по всему миру и была признана одним из ведущих производителей высококачественных научных материалов и лабораторных принадлежностей. 4E's Scientific продает научный инструмент и лабораторные принадлежности, такие как одноканальная Регулируемая Пипетка для объема, многоканальная Регулируемая Пипетка для объема, подставка для пипетки, магнитная мешалка 7 Дюймов, 5 дюймов, мини-размер, Вихревой миксер, центрифуга.
Сертифицировано по ISO9001:200 и ISO13485:2003, мы ориентируемся на надежное качество наиболее эффективным способом. Мы заботимся о наших продуктах и ценим наших клиентов
Компания FOUR E'S SCIENTIFIC основана для обслуживания лабораторного рынка по всему миру и была признана одним из ведущих производителей высококачественных научных материалов и лабораторных принадлежностей. 4E's Scientific продает научный инструмент и лабораторные принадлежности, такие как одноканальная Регулируемая Пипетка для объема, многоканальная Регулируемая Пипетка для объема, подставка для пипетки, магнитная мешалка 7 Дюймов, 5 дюймов, мини-размер, Вихревой миксер, центрифуга.
Сертифицировано по ISO9001:200 и ISO13485:2003, мы ориентируемся на надежное качество наиболее эффективным способом. Мы заботимся о наших продуктах и ценим наших клиентов
Трекер стоимости
Отзывы покупателей
Новые отзывы о товарах
Заказывала часы сыну в подарок, очень понравилась эта модель. Продавец ответил на все дополнительные вопросы, сразу отправил товар после оплаты.... Читать отзыв полностью...
Давно подыскивала сандалии с такими завязками, чтобы они заплетались выше стопы. В этих на первый взгляд, понравилось все - неброский,... Читать отзыв полностью...
Очень красивое, элегантное украшение! можно подарить в качестве подарка,а так же как и помолвочное!себе заказывала в качестве подарка, очень понравилось!... Читать отзыв полностью...
Нарядилась на свадьбу в это платье, и чувствовала себя без преувеличения, королевой. Вблизи оно просто супер - тончайшее кружево, белоснежная... Читать отзыв полностью...
Пару слов хочу сказать о этих монетах, потому как выписала их в подарок племяннику, он уже много лет собирает их.... Читать отзыв полностью...
Тщательно продуманный дизайн и отличное качество звука этих мини-наушников ставит их в один ряд с более крупными моделями...Впечатля юще мощное... Читать отзыв полностью...

















Заказала эту футболку, под свои джинсы. Товар пришел а отличном состоянии. Футболка идеально подошла по размеру. После стирки не села,... Читать отзыв полностью...